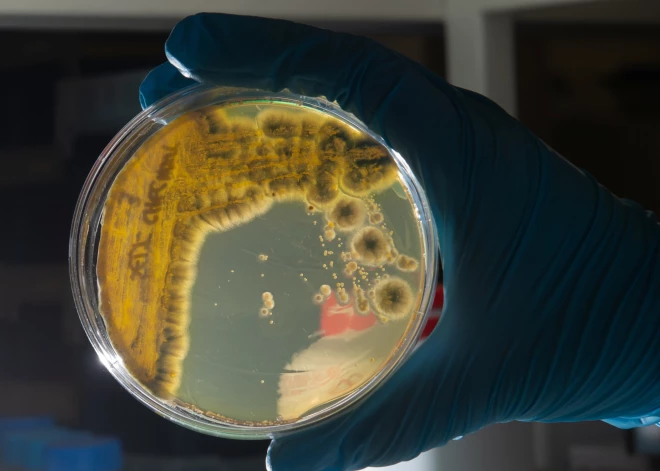
Может ли опасная кишечная инфекция охватить всю Латвию - мнение специалиста

Может ли опасная кишечная инфекция охватить всю Латвию - мнение специалиста

Вспышка инфекции кишечной палочки, произошедшая в настоящее время, не представляет собой проблему такого масштаба, чтобы охватить всю страну — конкретный продукт питания или блюдо рано или поздно либо выбрасывается, либо съедается, и поэтому бактерии не могут широко распространиться в обществе, считает инфекционист, профессор Университетской клинической больницы имени Паула Страдиня Уга Думпис.
«Не должно быть так, что инфекция распространится по всей Латвии», — заявил Думпис. Он предположил, что если в ближайшую неделю не будет зафиксировано большого количества новых случаев заражения, то вспышка может скоро завершиться.
В то же время, если число заболевших продолжит расти, будет легче найти источник инфекции или конкретный продукт, который мог ее вызвать, отметил Думпис.
«Важно понять, появляются ли в ближайшее время новые случаи, или мы все еще сталкиваемся с последствиями», — подчеркнул он.
Как сообщалось ранее, по состоянию на 3 апреля зарегистрированы 58 заболевших, в том числе семь взрослых. В Риге — 27 случаев, в Сигулдском крае — десять, в Адажском крае — восемь, в Цесисском крае и Лиепае — по три, в Саласпилском и Кекавском краях — по два, а в Елгавском, Ропажском и Южнокурземском краях — по одному, согласно данным, предоставленным Центром профилактики и контроля заболеваний (SPKC).
Случаи заражения зарегистрированы в 28 образовательных учреждениях — 26 детских садах и двух начальных школах.
Проведено обследование 153 контактных лиц, всего определено около 900 контактных лиц в учебных заведениях и по месту жительства.
В Детской клинической университетской больнице (BKUS) с подтвержденной инфекцией E.coli в настоящее время проходят лечение 16 детей: 11 из них — в инфекционном отделении, пятеро — в отделении интенсивной терапии.
Эпидемиологи, проводящие расследование случаев, работают в нескольких направлениях и уже провели ряд масштабных мероприятий, сообщили в SPKC.



